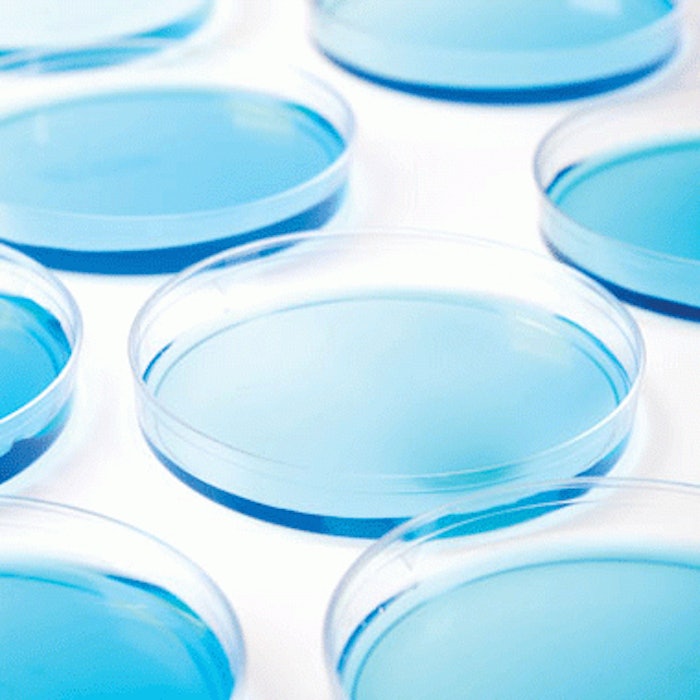

The most important scientific discovery related to topical skincare products during 2012 may have come from researchers at the Karolinska Institutet in Solna, Sweden. By using an entirely new experimental approach involving rapidly freezing tiny skin samples and studying them under a low-temperature electron microscope, the team was finally able to describe the stratum corneum at the molecular level. This enables scientists to see, for the first time, how the skin’s barrier function works and how it might be circumvented.
“We can now construct computer simulations to help us find out which substances have to be added to different drugs to open up the skin,” said Lars Norlén, associate professor at Karolinska Institutet’s Dermatology and Venereology Unit in a press statement released by the Institutet in April. “We hope to one day be able to administer regular drugs like insulin and antibiotics this way.” The study, published in the May issue of the Journal of Investigative Dermatology, also highlights the potential for developing more effective antiaging topical formulations.
A second breakthrough came in July 2012 when Chad Mirkin, director of Northwestern’s International Institute for Nanotechnology, reported using nucleic acid nanoparticles and topical moisturizers to penetrate the stratum corneum and deliver gene regulation technology directly to cells. The technology is detailed in “Topical Delivery of siRNA-based Spherical Nucleic Acid Nanoparticle Conjugates for Gene Regulation,” an article appearing in the Proceedings of the National Academy of Science (July 24, 2012). This was the first published investigation demonstrating the ability of nanoparticles to carry therapeutic payloads deep into the dermis. In this case the nanostructures were designed to target epidermal growth factor receptor (EGFR), a biomarker associated with a number of skin cancers, but similar nanostructures could just as easily target biomarkers associated with wrinkles in aging skin.
Cutting-edge discoveries like these indicate where skincare may be headed, but where are we today? What is the state of the art when it comes to today’s products and their purported use of stem cells, growth factors, DNA guided formulations and nano delivery systems? We spoke with four industry insiders and combed the literature to discover the top trends of 2012 and the facts behind the headlines.
Image copyright istockphoto.com
[PAGEBREAK]
Trend 1: Stem Cell Technology
Marketing materials for skincare products would have us believe that stem cells from plants as diverse as ancient Swiss apples and reishi mushrooms hold the answer to younger-looking skin. Most scientists aren’t buying it. First of all, plant stem cells are very different from human stem cells. Their meristem system produces undifferentiated cells that can go on to become any part of the plant. These stem cells grow readily in a laboratory setting and can be used to produce biological compounds with unique properties. It is these compounds, not the plant stem cells, that are being used in skincare products.
“Some major companies are working in this area and showing some interesting results,” says Rahul Mehta, PhD, vice president of research and development, SkinMedica (www.skinmedica.com). “Some plant stem cell extracts are high in antioxidants and may be useful in improving certain skin conditions, but they are source dependent, and we need to see a lot more evidence.”
What about human skin cells? It turns out they cannot be used in skincare products either. “No living material can be,” explains Simon Craw, PhD, executive vice president, business development, International Stem Cell Corporation, parent company of Lifeline Skin Care (www.lifelineskincare.com). “What we use are the proteins, peptides and enzymes extracted from human stem cells. These molecules stimulate your own skin cells by sending messages, for example, telling them to produce more collagen and elastin. In essence, they stimulate your body’s own skin cells to act like younger versions of themselves.”
Lifeline Skin Care begins with pluripotent human stem cells from unfertilized eggs and uses a patent-pending process to obtain the stem cell extract used in its products.
“Pluripotent stem cells have the potential to become any kind of cell, from those making up the cornea to those forming toenails. Lots of skincare products say they include stem cells, but it’s important to ask about the source,” says Craw. “Our research with pluripotent stem cells goes beyond addressing skin care. In other areas of the company that are more medically oriented, we are also looking at other areas of the body. For example, we are studying creating brain cells that might be therapeutic in treating Parkinson’s and other neurological diseases.”
The company recently reported results from an unpublished laboratory study investigating how its proprietary stem cell extract (HSC-X) helps the skin repair itself. The experiment shows the restorative effects of HSC-X by looking at how human skin cells recover after a simple injury. It consists of two petri dishes with human skin cells growing on fibroblast conditioned media. One dish was used as a control. The other was treated with Lifeline’s HSC-X. Both samples were then “wounded” by running a sharp object down the middle of the media. Microscopic examination of the media 24 hours later showed a 92% higher concentration of fibroblasts in the treated dish compared to the untreated control.
[PAGEBREAK]
“How we stabilize the active ingredients in a product is very important,” says Craw. “Many tend to degrade when exposed to outside elements. We find that nanosphere liposomes of a particular type similar to the skin matrix create an effective delivery system.”
Personal Cell Sciences (www.personalcellsciences.com) took stem cell-based topical skin care one step further in 2012 with the introduction of U Autologous skincare products. Instead of using cells from just anyone, the company extracts stem cells from your own fat and uses them to create a face cream based on your own growth factors and cytokines mixed with other ingredients such as green tea extract, caffeine and vitamins. Patients pay $3,000 for the initial procedure, which includes frozen storage for a cache of mesenchymal stem cells grown from those harvested from the patient. In addition, patients will have to pay $400 to $800 for each bottle of cream they purchase. An unpublished split-face trial sponsored by the company used computer analysis of photos to assess the 19 participants. After eight weeks of use, the participants showed 15% to 85% improvement (an average of a 25.6%) in wrinkle depth, and 75% of the 10 women who had tissue biopsies showed increased levels of elastin.
Trend 2: Human Growth Factors
Some scientists have bypassed stem cells and concentrated instead on human growth factors to create cutting-edge
skincare products. All human skin cells secrete one or more growth factors, which are responsible for wound healing and tissue regeneration, among other things.
“Some skincare formulations contain only one growth factor, while others contain multiple growth factors,” says Frank Dreher, PhD, chief scientific officer, Neocutis (www.neocutis.com). SkinMedica and Neocutis are the only two companies that use a mixture of natural human growth factors in their products. SkinMedica pioneered the category with TNS Recovery Complex, which uses NouriCel-MD, a combination of more than 100 growth factors, cytokines and soluble matrix proteins derived from a process using cultured neonatal human dermal fibroblasts.”
In its Bio-Restorative Day Cream, Neocutis uses PSP (processed skin cell proteins), which is a fetal fibroblast cell lysate. Like NouriCel-MD, PSP is a mixture of more than 100 human growth factors, cytokines and other proteins.
“Growth factors play a key role in the regulation of many physiological processes,” says Dreher. “Together with cytokines, they are important regulators of cell division, differentiation, adhesion and cell survival.”
[PAGEBREAK]
SkinMedica’s Mehta adds, “The skin is a complex system that can be affected via many pathways. Growth factors, especially in combination, are critical to the rebuilding process, as are retinoids and antioxidants. It’s very difficult to study how one molecule affects the skin in clinical trials. It makes more sense to look at overall benefits of a formulation that works through multiple pathways.”
Both growth factor products have been tested in limited clinical trials. The most recent study of the TNS Recovery Complex was reported in the September 2008 issue of the Journal of Drugs in Dermatology. The double-blind, placebo controlled study included 60 subjects who used either the TNS Recovery Complex or a vehicle hydrogel twice a day for six months. Participants were assessed by the investigator at three and six months. Photographs of the participants taken at six months were later assessed by an independent panel of three dermatologists. As assessed by the investigator, photodamage parameters such as fine wrinkling, mottled pigmentation and tactile roughness significantly decreased from baseline in the active group (26 subjects) after six months. Photographic evaluation showed a worsening of photodamage for the control group and either a slight improvement in photodamage after three months or substanitial prevention of worsening as indicated by a smaller change from baseline at six months. Participants with severe photodamage showed a statistically significant improvement when using the active formula for six months.
The most recent study of Neocutis Bio-restorative Skin Cream was reported in the June 2008 Journal of Cosmetic Laser Therapy. It involved 11 participants who applied the novel skin cream twice daily for six months. Punch biopsies were taken from the preauricular skin area of each before and after the treatment period. Clinical assessment recorded a 33% reduction in periorbital wrinkles and a 25% reduction in perioral wrinkles. Histologic evaluation indicated moderate changes in the epidermal thickness as well as an increased fibroblast density in the superficial dermis at six months. Ultrastructural changes consistent with new collagen formation were shown by electron microscopy.
[PAGEBREAK]
Trend 3: Holistic, Individualistic Approach
Zein Obagi, MD, dermatologist, and founder and medical director of ZO Skin Health (www.zoskinhealth.com), finds both stem cell and growth factor technology suspect. “Growth factors in skincare topicals have not been shown to penetrate in enough concentration to affect the dermis,” he says. “The same is true of stem cells. We really can’t say that we have an extract that can create collagen or fibroblasts. What we have are only pieces of the puzzle, not real answers.
“The skincare industry continues to sell dreams in a jar,” he continues. “I would like to see the entire industry come together to stop ‘quick fix’ products and, instead, address the functionality of skin as a whole. I don’t think all skincare companies are bad, I just think they are using the wrong concept. It is like losing weight—if you want to be fit, you exercise, of course, but you also need to eat healthy, drink water and take appropriate supplements. Creating healthy skin requires the same approach. The entire body must be ‘on program.’ I wish the industry would adopt this more holistic approach.”
What does work according to Dr. Obagi? “At age 30, cellular function slows. That’s when you start to get wrinkles and laxity. If you want to improve the skin, you need to restore the normal function of the cells. You need to go down to the dermis and activate the cells. The most studied and most promising agent for doing that is Retin A. It is the one substance with molecules small enough to penetrate the epidermis and reach skin receptors to stimulate the natural production of collagen and elastin. Retinol in high enough concentration with the right delivery system has been shown to reduce the signs of aging.”
In March 2012, Dr. Obagi introduced ZO Medical, a line of 11 products available exclusively through physicians. ZO Medical includes two cleansers, a toner, Cebatrol to help control acne, Brightenex with a blend of 1% retinol and melanin inhibitors for skin discoloration, Glycogent to help reduce inflammation, Retamax with retinol for antiaging, and four prescription-only products containing hydroquinone or tretinoin.
[PAGENREAK]
In January 2012, Elizabeth Ho and colleagues published results of a clinical trial comparing nonprescription tri-retinol 1.1% gradual release cream and prescription-only tretinoin 0.025% cream in a randomized, double-blind, controlled study of 34 subjects. They concluded that there were no significant differences in efficacy between the two groups (16 used tri-retinol and 18 used tretinoin), and both products significantly improved signs of photodamage, including wrinkles, laxity and skin tone. Both products were generally well-tolerated and 93% reported overall satisfaction with both products.
Our four panelists were in agreement that most skincare products still need additional study and more rigorous clinical trials. “Whether we’re talking about growth factors or antioxidants, we need clinical data on all of these elements and how they activate different rebuilding pathways,” Mehta says. “How each is stabilized and delivered is equally as important. Lots of things need to be proven. For example, there are lots of retinoids in a variety of skincare products but retinoids cause irritation to the skin and are notoriously unstable. They need to be used in formulations that stabilize the retinoids and help reduce irritation.”
Linda Lewis is a contributing editor of MedEsthetics.










